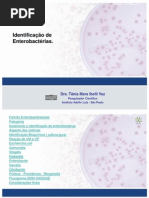

0% acharam este documento útil (0 voto)
220 visualizações38 páginasCaracterísticas e Reprodução dos Fungos
Enviado por
tqfinal2023Direitos autorais
© © All Rights Reserved
Levamos muito a sério os direitos de conteúdo. Se você suspeita que este conteúdo é seu, reivindique-o aqui.
Formatos disponíveis
Baixe no formato PDF, TXT ou leia on-line no Scribd
0% acharam este documento útil (0 voto)
220 visualizações38 páginasCaracterísticas e Reprodução dos Fungos
Enviado por
tqfinal2023Direitos autorais
© © All Rights Reserved
Levamos muito a sério os direitos de conteúdo. Se você suspeita que este conteúdo é seu, reivindique-o aqui.
Formatos disponíveis
Baixe no formato PDF, TXT ou leia on-line no Scribd